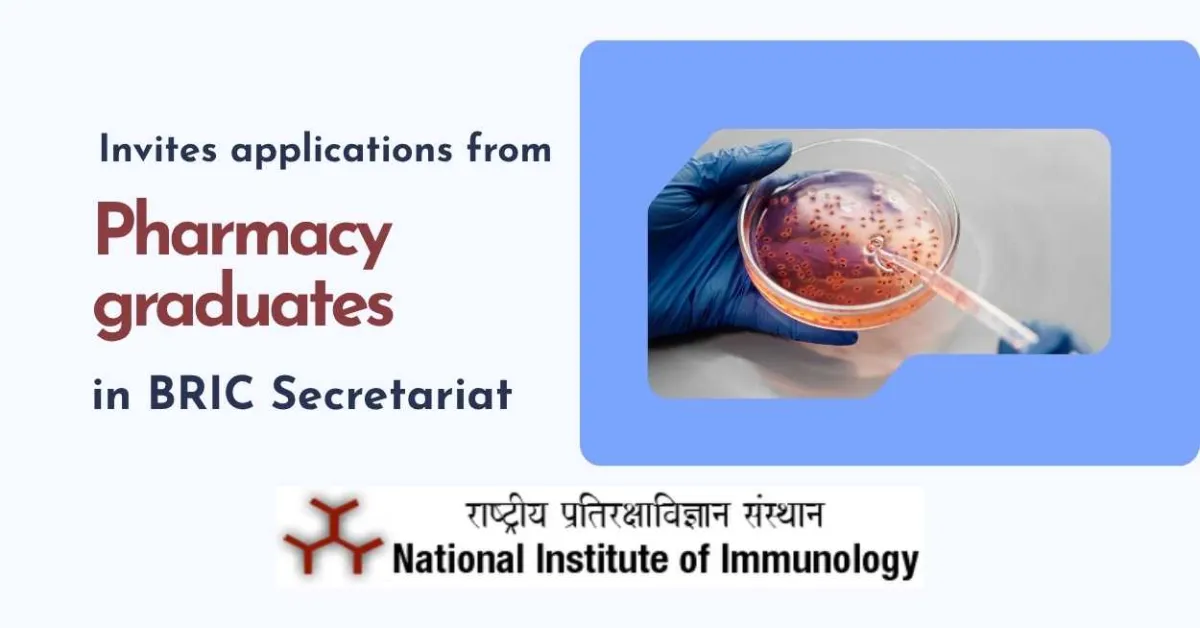
NII invites applications from Pharmacy graduates for working in BRIC Secretariat

The National Institute of Immunology (NII) is committed to advanced research with a view to understand body's defense mechanisms for developing modalities of immune system manipulation that can intervene with disease processes. The institute’s research thrust areas under immunology and related disciplines cluster in four main themes, namely, infection and immunity, molecular design, gene regulation and reproduction and development, where cutting edge research in modern biology is being carried out employing multiple overlapping disciplines of biochemistry, molecular biology, cell biology and structural biology.
NII invites applications for the following manpower positions for the Administration/Finance & Accounts/Scientific Coordination department of Biotechnology Research & Innovation Council (BRIC) purely on contract basis for working on fulltime basis in BRIC Secretariat at New Delhi.
Consultant : 1 Post
Age Limit : Below 55 Years
Essential Criteria : Bachelor's Degree from a recognized University with at least 10 years of relevant experience in work of General Administration and Establishment in Government or Autonomous Bodies or PSUs etc. OR Master's Degree from a recognized University with at least 6 years of relevant experience in work of General Administration and Establishment in Government or Autonomous Bodies or PSUs etc. OR Ph.D. degree in Science or Engineering from a recognized University
Duties & Responsibility :
• Carrying out continuous review monitoring, applicability, interpretation of all relevant rules and regulations pertaining to service matters or financial regulations and assisting in preparing input of the division of annual report, progress report etc.
• Coordination with research institutes of BRIC for management for Inter Institutional projects, drafting of scientific advisory committee reports, project documents, Science Communication and liaison with Industries etc.
• Organizing High Level Committees (HLC) meetings for scientific / administrative purposes. Preparing agenda points, issuing minute/proceedings and follow up. Preparation of briefs and notes etc.
• Monitoring and addressing of ongoing scientific schemes and programme, to provide support in addressing policy issues.
Young Professional : 1 Post
Age Limit : Below 40 Years
Essential Criteria :
A Master’s Degree OR B.E / B.Tech / B.Pharm OR PGD in Management with at least 4 years of experience with having minimum 60% marks
OR
The candidate should either have a Bachelor’s degree in any subject with at least 10 years of experience with having minimum 60% marks.
Candidates with experience in the relevant areas of HR, Management or coordination/Management of large scientific project shall be preferred.
Duties & Responsibility :
• Participate in meeting, events, conference related to Secretariat coordinate administrative preparation ensuring all necessary documents and prepare and distribute relevant post-event document like meeting minute’s action plan summary document as required.
• Also take up activities including monitoring and addressing of ongoing scientific schemes and programme, to provide support in addressing policy issues.
Monthly Remuneration : Consultant : Rs.80,000/-per month In case of Re-employment, a fixed monthly amount shall be admissible as pay. which would be arrived at, by deducting the basic pension from the pay drawn at the time of retirement. The amount of remuneration so fixed shall remain unchanged for the term of the contract. There will be no annual increment / percentage increase during the contract period.(As per DOE's OM dated 09.12.2020)
Young Professional : Rs.60,000/-per month.
Leave : Paid leave of absence may be allowed at the rate of 1.5 days for each completed month of Service. Accumulation of leaves beyond a calendar year shall not be allowed.
Other terms and conditions : The terms and conditions of engagement of the manpower shall be in accordance to the instructions issued from time to time by Govt. of India.
General Terms & Conditions:-
1. The initial engagement of Consultant/Young Professional shall be one year from the date of appointment. After expiry of engagement, initial engagement shall be extended further as per requirement based on satisfactory performance and mutual consent.
2. The appointment of Consultant/Young Professional would be on full time basis and he/she would not be permitted to take up any other assignment either part time or full time during the engagement with the Institute.
3. The appointment of Consultant/Young Professional is of a temporary nature and can be terminated by giving not less than one months’ notice on either side at anytime without assigning any reason.
4. The Consultant/Young Professional shall be paid a fixed consolidated monthly as per the Guidelines of GOI issued/amended from time to time. No other allowance shall be admissible.
5. The Consultant/Young Professional shall be completely accountable for any advice/service rendered by them during their engagement in the Institute in view of the norms of ethical business and professionalism.
6. Merely fulfilling the essential qualification/experience does not guarantee to be called for interview.
7. The posts are filled-upon purely temporary basis & the candidate will have no right to claim for any type of Permanent Employment or continuation of his/her services in any other project/assignment.
8. The prescribed age limit, educational qualifications, experience etc. shall be reckoned as on the last date of receipt of applications.
9. Interested and Eligible candidates are required to submit application fee of Rs. 200/- through online mode/internet banking as per the following details
Name of Account : National Institute of Immunology Aruna Asaf Ali Marg NewDelhi- 110067
Details of Bank : Canara Bank Jit Singh Marg NewDelhi-110067
Account Number : 1484101001636
Account Type : Savings
IFSC Code : CNRB0001484
10. Applicants should attach proof of payment in respect of application fee along with the application. Applications received without requisite application fee or not in the prescribed application format shall not be entertained under any circumstances.
11. Female candidates, SC/ST, PwD and Ex-Servicemen candidates are exempted from payment of application fee.
12. Applications not in conformity with the requirement indicated in the advertisement, are liable to be rejected.
13. The application in the prescribed format along with self-attested photocopies of all educational qualifications, experience certificates; caste certificate, recent passport size photo, payment proof of application fee etc. may be submitted by email to admin2@nii.ac.in and the Hard Copy maybe submitted through speed/registered speed post only to the Director, National Institute of Immunology, Aruna Asaf Ali Marg, New Delhi-110067. The applications received after the last date will not be entertained.
14. If at any point of time, it is found that the information furnished by the candidate was incorrect in any respect or forged/fabricated documents were presented by any candidate, his/her candidature will be cancelled and in case the candidate has already joined the post, his/her services shall be summarily terminated.
15. Candidates working in Central Govt./State Govt./PSUs/Autonomous Bodies have to submit their application through proper channel OR furnish NOC at the time of interview, failing which they shall not be considered for interview.
16. If any applicant has desired experience in the relevant area any of the DBT AI’s, the age relaxation for the recruitment process will be considered by deducting the time spent in contractual employment in the Institute from the maximum age prescribed for the post applied for.
17. No TA/DA shall be paid for attending the interview.
LAST DATE FOR APPLYING TO THE ABOVE POSTS : 09.04.2026
See All B.Pharm Alerts M.Pharm Alerts Ph.D Alerts Delhi Alerts
See All Other Jobs in our Database
Subscribe to Pharmatutor Job Alerts by Email